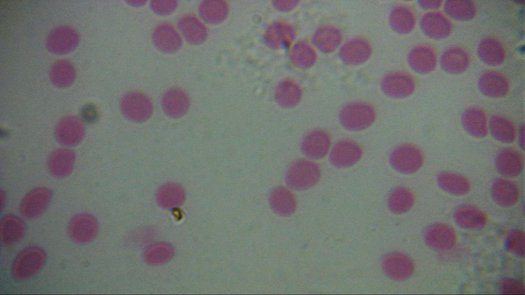

|
ZAMÓW DO PUNKTU ODBIORU:
|
|
|
359 zł
|
|
cena netto: 291,87 zł
|
|
na raty od: 7 zł
|
| |
 Sklep internetowy: Sklep internetowy:
● dostępne od ręki
Sklep w Warszawie: 10+ szt.
● dostępne od ręki
Sklep w Chorzowie: 4 szt.
● dostępne od ręki
|
|
Ten produkt dostarczamy bezpłatnie kurierem (za pobraniem i przy wpłacie na konto). Zakupione równocześnie artykuły też wyślemy GRATIS !
Nowe, niższe raty (0,4% msc).
Sprawdź wartość raty i kup już dziś:

Levenhuk 2L to nowoczesny, prosty w obsłudze i funkcjonalny mikroskop zaprojektowany dla osób szukających dobrego optycznie i niedrogiego mikroskopu "na start".
• szklana optyka zapewnia jasny i ostry obraz
• lekki korpus z tworzywa
• duże, precyzyjne pokrętło ostrości
• podwójny system oświetlenia z regulacją jasności: przechodzące oraz odbite (górne) - oświetlenie odbite umożliwia obserwowanie obiektów nieprzeźroczystych
• zasilanie sieciowe 230 V oraz bateryjne w zestawie
• duży zakres powiększeń: od 40x do 400x (można dokupić okular 16x i zyskać powiększenie 640x)
• stolik przedmiotowy z łapkami do przytrzymania szkiełka z preparatem
• w komplecie zestaw pięciu gotowych preparatów (można rozpocząć obserwację od razu po rozpakowaniu) oraz narzędzia preparacyjne do przygotowania własnych preparatów i wyhodowania krewetek słonowodnych
Mikroskop Levenhuk 2L umożliwia prowadzenie obserwacji prostych preparatów biologicznych (tkanki roślinne i zwierzęce), owadów, minerałów, roślin, a także znaczków, monet, kamieni szlachetnych i niewielkich układów elektronicznych.
• głowica: monokularowa pochylona pod kątem 45°
•
średnica tubusu: 23,2 mm
•
okulary: WF 10x 23 mm
•
obiektywy: achromatyczne 4x, 10x, 40x
•
powiększenia: 40x, 100x, 400x
•
korpus: z tworzywa
•
koło filtrowe: 6 diafragm pod stolikiem o różnych aperturach
•
regulacja ostrości: makro
•
oświetlenie: LED, górne / dolne z regulacją jasności
•
kondensor: NA 0,65
•
stolik przedmiotowy: 90 x 90 mm, z łapkami do mocowania preparatu
• wymiary opakowania zewnętrznego (podstawa x wysokość): 190 x 135 x 365 mm
•
zasilanie: 220V 50Hz lub 3 baterie AA
• waga: 630 g (mikroskop) / 940 g (cały zestaw bez opakowania)
Do mikroskopu dołączono podstawowy zestaw preparacyjny K50 z książeczką instruktażową.
•
gotowe preparaty (5 sztuk: noga muchy, epiderma cebuli, przekrój przez łodygę bawełny, przekrój pnia sosny, przekrój rośliny dwuliściennej)
•
szkiełka przedmiotowe podstawowe (5 sztuk)
•
plastikowe pudełko na preparaty
•
pęseta metalowa
•
pipeta
•
prosty mikrotom ręczny do przygotowywania cienkich preparatów
•
zestaw akcesoriów do przygotowania eksperymentu z hodowlą krewetek słonowodnych
•
przeciwkurzowy pokrowiec na mikroskop
•
zasilacz sieciowy 5 V oraz 3 baterie AA ("paluszki")
dożywotnia gwarancja producenta, 2 lata gwarancji sklepu





poniżej - zdjęcia wykonane mikroskopem Levenhuk 2L i kamerą Bresser 2 Mpix USB; preparaty - wybrane biologiczne preparaty z naszej oferty a także druk, długopis kulkowy, moneta - dla światła odbitego, przy różnych powiększeniach (naciśnij na obraz aby zobaczyć w pełnym rozmiarze)
obiekty w świetle przechodzącym

obiekty w świetle przechodzącym






|



